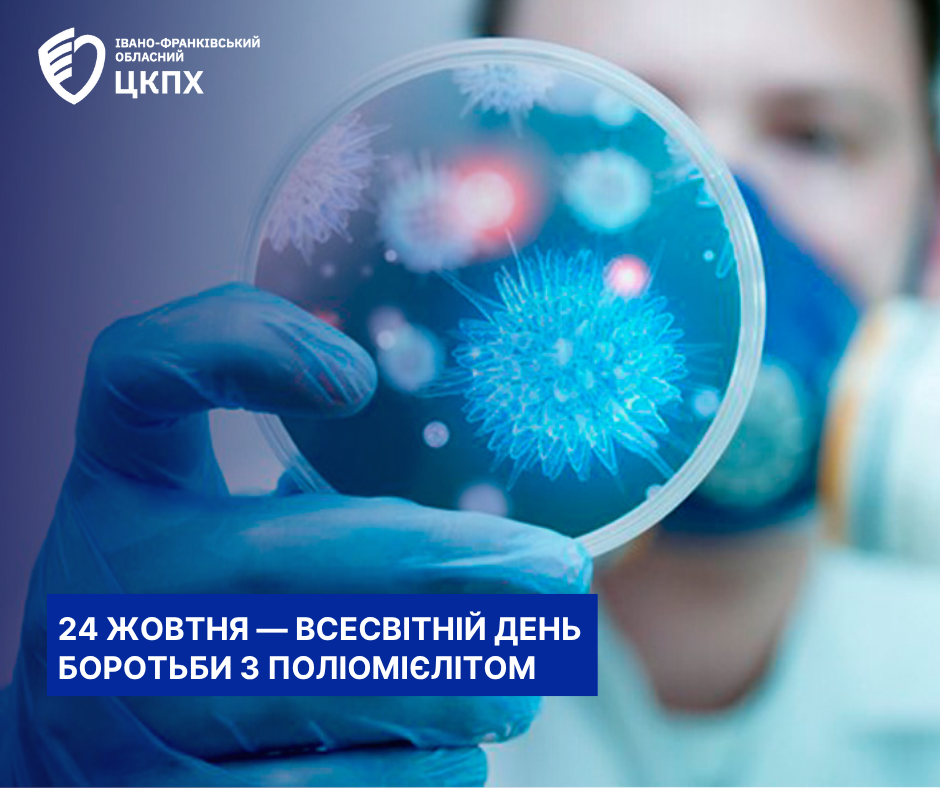

24 жовтня — Всесвітній день боротьби з поліомієлітом
24 жовтня 2025
Поліомієліт — небезпечна вірусна інфекція, що уражає нервову систему та може призвести до паралічу, втрати рухливості чи навіть смерті. Найчастіше хворіють діти до 5 років, однак невакциновані дорослі теж можуть заразитися.
Світ наблизився до ліквідації поліомієліту, проте вірус досі циркулює у декількох країнах — Афганістані та Пакистані. Окремі випадки виявлення вірусу у стічних водах фіксують і в деяких країнах Європи та Середземномор’я. Це нагадує: поки поліовірус існує хоча б десь, ризик його повернення є всюди.
В Україні востаннє спалах поліомієліту фіксувався в жовтні 2021 року, який ВООЗ оголосила завершеним восени 2023 року. Завдяки вакцинації та посиленому епіднагляду поширення вірусу вдалося зупинити. Проте ризик завезення поліовірусу залишається реальним — через активну міграцію населення та воєнні переміщення.
Поліовірус передається фекально-оральним шляхом — через брудні руки, заражену воду чи їжу. У довкіллі вірус може виживати кілька тижнів і поширюватися без жодних симптомів. Спершу хвороба може виглядати як звичайна застуда, але згодом вірус здатен викликати параліч кінцівок або дихальних м’язів.
Поліомієліт не має специфічного лікування. Вірус руйнує рухові нейрони стовбура мозку, спинного мозку та рухової кори, реабілітація може лише зменшити наслідки.
Єдиний надійний спосіб захисту — вакцинація.
Щеплення проти поліомієліту входить до Календаря профілактичних щеплень в Україні. Вакцини, які зареєстровані в Україні — безпечні, ефективні й перевірені десятиліттями. Завдяки їм мільйони дітей у світі ніколи не дізналися на своєму прикладі, що таке поліомієліт.
Несіть відповідальність за своє здоров’я — робіть вибір на користь профілактики.